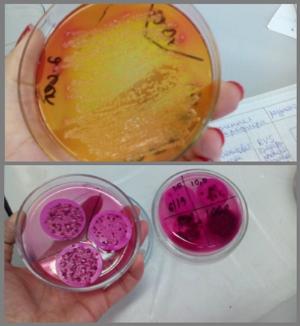
������������� - ���� �� ������������ ����������� ������-������������ ��������� XXI ����

Биотехнология - одно из приоритетных направлений научно-технического прогресса XXI века
28.07.2017
28.07.2017
Приглашаем на направление подготовки 19.03.01 «Биотехнология» (бакалавриат и магистратура).
Биотехнология является приоритетным направлением научно-технического прогресса XXI века. Прикладной частью биотехнологии является биотехнологическое производство, развивающееся на базе современных инженерных технологий. Объектами профессиональной деятельности выпускника данного направления являются ферменты и биологически активные химические вещества, приборы и оборудование для исследования свойств микроорганизмов, клеточных культур, получаемых путем биосинтеза веществ в лабораторных и промышленных условиях, биомассы, оборудование для проведения биотехнологических процессов, средства контроля сырья и готовой продукции, регламенты на производство продуктов биотехнологии, международные стандарты, средства оценки состояния окружающей среды и защиты её от влияния промышленного производства. При обучении в бакалавриате, магистратуре изучают дисциплины, которые востребованы в промышленности - биокоррозионная активность почвогрунтов на трассах нефтепровода, биотехнологические аспекты мониторинга окружающей среды, очистка сточных вод. биосорбционные очистные технологии, биоремедиация загрязненных нефтью и нефтепродуктами объектов окружающей среды, биотехнологические процессы рекультивации загрязненных металлами почв, оценка воздействия природообустройства и водопользования на природную среду.
Выпускники направления "Биотехнология" кафедры Химическая технология и биотехнология подготовлены к производственно-технологическим видам деятельности: эксплуатации и управлению качеством биотехнологического производства в соответствии с требованиями российских и международных стандартов качества, технологии получения продукции с использованием микробиологического синтеза, биокатализа, генной инженерии, нанобиотехнологий, организации и проведению контроля качества сырья, промежуточных продуктов и готовой биотехнологической продукции.
Подробнее >>

